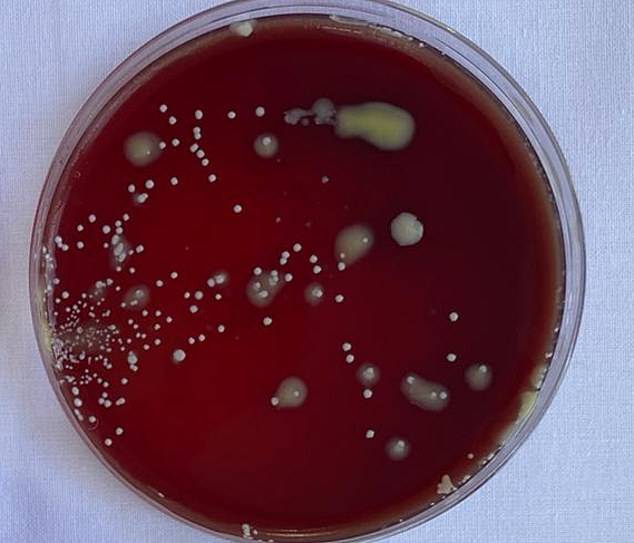
Plato de Petri al que se le tosió sin mascarilla

La iniciativa COVAX de la Organización Mundial de la Salud (OMS) busca que todos los países tengan acceso a la vacuna del Coronavirus Covid-19. A Trump no le interesa eso.
La Organización Mundial de la Salud (OMS) se ha convertido en un punto de referencia obligado para los gobiernos de todo el mundo en esta pandemia del Coronavirus Covid-19.
Sin embargo no todas las naciones han cooperado de manera equilibrada, ni han hecho mucho caso a las recomendaciones del organismo.
Ahí está la política contradictoria del uso de mascarillas faciales en México o el asunto de la iniciativa COVAX .
Este último proyecto busca crear un esfuerzo coordinado en todo el mundo para que todos los países, incluso los que no tienen recursos, tienen acceso a la vacuna del Coronavirus Covid-19 cuando esta exista.
Desde hace un mes hemos visto a la OMS comenzará a tener fricciones con distintos gobiernos por esta iniciativa y ahora Estados Unidos, con la administración de Donald Trump, se ha bajado del tren.
¿Otra acusación de Trump?
Según reporta el Washington Post, la propia Casa Blanca ha confirmado que Estados Unidos no participará en el proyecto COVAX.
Todo básicamente debido a que la OMS es quien lo gestiona y esta es corrupta ya que tiene vínculos con los malvados chinos, o algo así:

Estados Unidos continuará involucrando a nuestros socios internacionales para asegurar que derrotamos este virus, pero no nos veremos limitados por organizaciones multilaterales influenciadas por la corrupta Organización Mundial de la Salud y China.
Este presidente no escatimará gastos para garantizar que cualquier vacuna nueva mantenga el estándar de oro de nuestra propia FDA en cuanto a seguridad y eficacia, se a fondo y salve.
Es lo que dijo el portavoz de la Casa Blanca, Judd Deere, en un comunicado con la postura oficial de ese gobierno sobre ese tema.
Estados Uni dos cuenta actualmente con más de 6 millones de casos de contagio reportados. Esta decisión los aislaría del proyecto COVAX, al que ya se apuntaron 170 naciones.
Pero tienen su propia iniciativa llamada Operación Warp Speed. Los laboratorios Moderna y Pfizer tienen proyectos activos de vacunas experimentales en Estados Unidos y están por iniciar pruebas de fase 3.
Se veía venir
Eso se veía venir, ya que desde abril de 2020 la administración de Trump cortó por completo el financiamiento a la OMS.
Desde entonces la relación de este país con la organización no ha sido el más cordial y este anuncio, con todo y sus acusaciones, viene a confirmar que no pasa por su mejor momento.
.

[19659010] Es lo que señala el profesor Philippe Karoyan, del LBM, destacando que ya cuentan con una patente registrada y que su producción no sería tan costosa.
[19659010] Es lo que señala el profesor Philippe Karoyan, del LBM, destacando que ya cuentan con una patente registrada y que su producción no sería tan costosa.




























